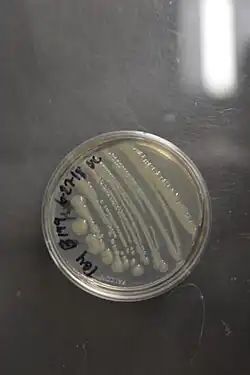

Klebsiella oxytoca
| Klebsiella oxytoca | |
|---|---|
| |
| Gram stain | |
| Scientific classification | |
| Domain: | Bacteria |
| Kingdom: | Pseudomonadati |
| Phylum: | Pseudomonadota |
| Class: | Gammaproteobacteria |
| Order: | Enterobacterales |
| Family: | Enterobacteriaceae |
| Genus: | Klebsiella |
| Species: | K. oxytoca
|
| Binomial name | |
| Klebsiella oxytoca (Flügge 1886) Lautrop 1956
| |
Klebsiella oxytoca is a Gram-negative, rod-shaped bacterium that is closely related to K. pneumoniae, from which it is distinguished by being indole-positive; it also has slightly different growth characteristics in that it is able to grow on melezitose, but not 3-hydroxybutyrate. It was first described in 1886 when it was isolated from sour milk and named Bacillus oxytocus perniciosus (from Greek oxus 'sour' + -tokos 'producing').[1]
Klebsiella oxytoca is characterized by negative methyl red, positive VP, positive citrate, urea and TSI gas production, is AA, and negative for TSI sulfide, DNAse, growth on sulfide-indole motility medium and the phenylalanine deaminase test.
It is a diazotroph, able to colonise plant hosts and fix atmospheric nitrogen into a form which the plant can use. Association of K. oxytoca with the barley rhizosphere during an entire vegetative period has been demonstrated. The bacteria adhere strongly to root hairs, and less strongly to the surface of the zone of elongation and root cap mucilage.[2]
Like other enterobacteria, it is capable of acquiring antibiotic resistance, and isolates have been shown to produce extended-spectrum beta-lactamases as well as carbapenemases.[3]
Industrial uses
Klebsiella oxytoca has shown promise in industrial ethanol fuel production,[4] and is referenced as being used to produce hydrogen in patents filed by Nanologix, Inc.
Clinical significance and epidemiology
Infections can result in colitis and sepsis.[5]
Outbreaks of antibiotic-resistant Klebsiella oxytoca have occurred in multiple hospitals and ICUs throughout the world, and handwashing stations have been identified as a potentially important environmental reservoir.[6]
Ecology
Houseflies (Musca domestica) have a mutualistic relationship with the bacterium K. oxytoca. This bacterium can live on the surface of the housefly eggs and has a deterrent effect on the fungi growing in manure, thus benefiting the fly larvae which are competing with the fungi for nutrients.[7]
References
- ^ Flügge, Carl (1886). Die Mikroorganismen. Leipzig: F.C.W. Vogel.
- ^ Brisse S, Grimont F, Grimont PA (2006). Prokaryotes. New York, NY: Springer New York. pp. 159–196. ISBN 9783540325246.
- ^ Hoenigl, Martin; Valentin, Thomas; Zarfel, Gernot; Wuerstl, Benjamin; Leitner, Eva; Salzer, Helmut J. F.; Posch, Josefa; Krause, Robert; Grisold, Andrea J. (2012-04-01). "Nosocomial Outbreak of Klebsiella pneumoniae Carbapenemase-Producing Klebsiella oxytoca in Austria". Antimicrobial Agents and Chemotherapy. 56 (4): 2158–2161. doi:10.1128/AAC.05440-11. ISSN 0066-4804. PMC 3318378. PMID 22290949.
- ^ Dien B, Cotta M, Jeffries T (2003). "Bacteria engineered for fuel ethanol production: current status". Appl Microbiol Biotechnol. 63 (3): 258–66. doi:10.1007/s00253-003-1444-y. PMID 13680206. S2CID 10340191.
- ^ Högenauer C, Langner C, Beubler E, et al. (December 2006). "Klebsiella oxytoca as a causative organism of antibiotic-associated hemorrhagic colitis". N. Engl. J. Med. 355 (23): 2418–26. doi:10.1056/NEJMoa054765. PMID 17151365.
- ^ Leitner, Eva; Zarfel, Gernot; Luxner, Josefa; Herzog, Kathrin; Pekard-Amenitsch, Shiva; Hoenigl, Martin; Valentin, Thomas; Feierl, Gebhard; Grisold, Andrea J. (2015-01-01). "Contaminated Handwashing Sinks as the Source of a Clonal Outbreak of KPC-2-Producing Klebsiella oxytoca on a Hematology Ward". Antimicrobial Agents and Chemotherapy. 59 (1): 714–716. doi:10.1128/AAC.04306-14. ISSN 0066-4804. PMC 4291428. PMID 25348541.
- ^ Lam, Kevin; Thu, Kelsie; Tsang, Michelle; Moore, Margo; Gries, Gerhard (2009). "Bacteria on housefly eggs, Musca domestica, suppress fungal growth in chicken manure through nutrient depletion or antifungal metabolites". Naturwissenschaften. 96 (9): 1127–1132. Bibcode:2009NW.....96.1127L. doi:10.1007/s00114-009-0574-1. PMID 19636523. S2CID 187752.
External links
- Klebsiella+oxytoca at the U.S. National Library of Medicine Medical Subject Headings (MeSH)
- Type strain of Klebsiella oxytoca at BacDive – the Bacterial Diversity Metadatabase
